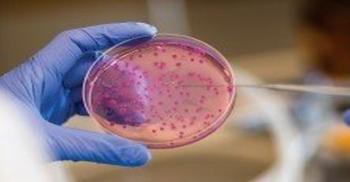

Advertisement
Advertisement
Trending on Infection Control Today
1
Superbug-Related Deaths: A Call to Action for Hospitals
2
Announcing the 2025 Infection Control Today Educator of the Year Award Winner: Patricia Montgomery, MPH, RN, CIC, FAPIC
3
The Invisible Threats: An IP's Guide to Advocating for Sterile Processing
4
Wastewater as an Early Warning System: What 2 Years of SARS-CoV-2 Surveillance in Warsaw Reveal
5